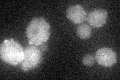
YMR102C
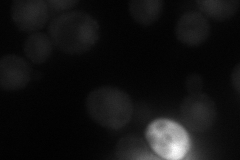
YMR102C
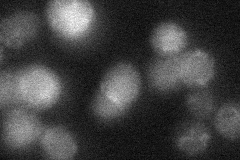
YMR102C
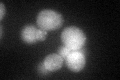
YMR102C
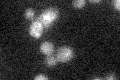
YMR102C

View description
Protein of unknown function; transcription is activated by paralogous transcription factors Yrm1p and Yrr1p along with genes involved in multidrug resistance; mutant shows increased resistance to azoles; YMR102C is not an essential gene
Localization:
Intensity:
Fold change:
Significance:
-
C’ GFP library in SD
cytosol21.93 -
N' NOP1pr-GFP in SD
cytosol,punctate,nucleus50.7785 -
N' TEF2pr-mCherry in SD

punctate,nucleus54.6954 -
N' NATIVEpr-GFP in SD
cytosol,punctate24.6822 -
N' TEF2pr-VC and Cyto-VN in SD

#N/A0 -
C’ GFP library in SD+DTT
cytosol30.221.37Yes -
C’ GFP library in SD+H2O2

cytosol22.581.02No -
C’ GFP library in Starvation Media
cytosol23.481.07No -
C’ GFP library on the background of Pup2-DaMP

cytosol -
C’ GFP library on the background of CCT mutant

cytosol21.71990.989931No
